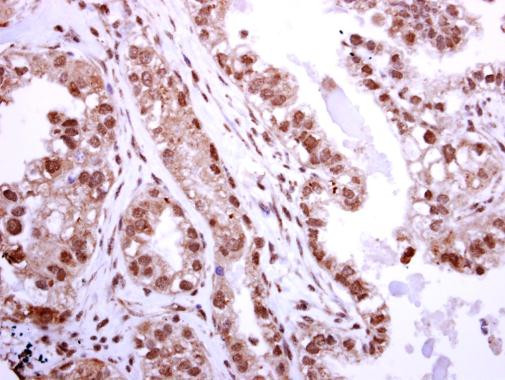
BRIP1 Antibody in Immunohistochemistry (Paraffin) (IHC (P))

Search
Invitrogen
BRIP1 Polyclonal Antibody
{{$productOrderCtrl.translations['antibody.pdp.commerceCard.promotion.promotions']}}
{{$productOrderCtrl.translations['antibody.pdp.commerceCard.promotion.viewpromo']}}
{{$productOrderCtrl.translations['antibody.pdp.commerceCard.promotion.promocode']}}: {{promo.promoCode}} {{promo.promoTitle}} {{promo.promoDescription}}. {{$productOrderCtrl.translations['antibody.pdp.commerceCard.promotion.learnmore']}}
图: 1 / 2
BRIP1 Antibody (PA5-29889) in IHC (P)


产品信息
PA5-29889
宿主/亚型
分类
类型
抗原
偶联物
形式
浓度
规格
保存条件
运输条件
RRID
产品详细信息
Recommended positive controls: 293T, A431.
Store product as a concentrated solution. Centrifuge briefly prior to opening the vial.
靶标信息
BRIP1 (BRCA1 Interacting Protein C-terminal Helicase 1) is a gene situated on chromosome 17q22, covering 19 exons within its 184-kb coding region to encode a protein containing 1249 amino acids. BRIP1 is integral to the DNA repair processes, specifically through its interaction with the BRCA1 gene, and is involved in the Fanconi anemia complementation group J (FANC J). Mutations in BRIP1 have been identified, playing a role in cancer predisposition with a notable eightfold increased risk for ovarian cancer and associations with cervical cancer risk through its single nucleotide polymorphisms (SNPs). Amplifications and other mutations of BRIP1 are prevalent in a variety of cancers, and its expression involves significant correlations with copy number variations (CNV) and DNA methylation across numerous tumor types. BRIP1's expression is upregulated in certain contexts, which can contribute to cancer progression, as evidenced in the Omani population with breast cancer. These interactions validate its association with DNA damage repair, cell cycle, and metabolism across multiple cancer types.
⚠WARNING: This product can expose you to chemicals including mercury, which is known to the State of California to cause birth defects or other reproductive harm. For more information go to www.P65Warnings.ca.gov.
仅用于科研。不用于诊断过程。未经明确授权不得转售。